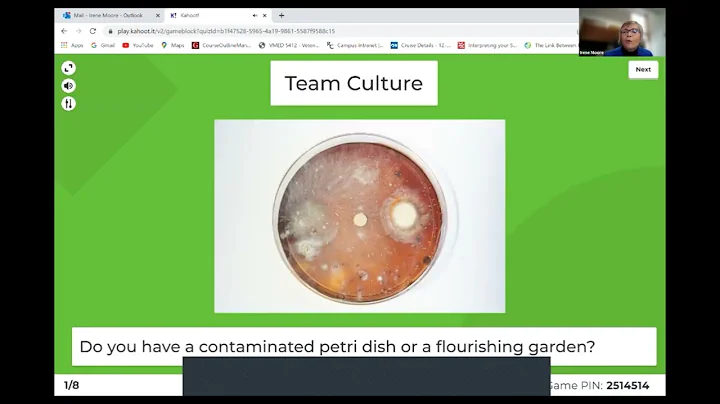

Domenic C Rigoglioso
age ~69
from Sterling, VA
- Also known as:
-
- Domenic Charles Rigoglioso
- Domenic O
Domenic Rigoglioso Phones & Addresses
- Sterling, VA
- Hawthorne, CA
- Washington, DC
- 6789 Louisburg Square Ln #31, Charlotte, NC 28210
- 11127 Gatemoore Way, San Diego, CA 92131
- Garfield, NJ
- Riverside, CA
- 6789 Louisburg Square Ln #3, Charlotte, NC 28210
Work
-
Company:Goodrich
-
Position:Senior counsel
Education
-
School / High School:Syracuse University
Ranks
-
Licence:California - Active
-
Date:1988
Industries
Aviation & Aerospace
Resumes

Senior Counsel
view sourceLocation:
2730 west Tyvola Rd, Charlotte, NC 28217
Industry:
Aviation & Aerospace
Work:
Goodrich
Senior Counsel
Senior Counsel
Lawyers & Attorneys

Domenic Charles Rigoglioso, San Diego CA - Lawyer
view sourceAddress:
11127 Gatemoore Way, San Diego, CA 92131
Licenses:
California - Active 1988
Education:
Syracuse University
Western State University College of Law
Western State University College of Law
Specialties:
Business - 100%
Get Report for Domenic C Rigoglioso from Sterling, VA, age ~69